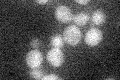
YHR169W
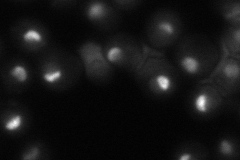
YHR169W
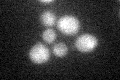
YHR169W

View description
ATPase, putative RNA helicase of the DEAD-box family; component of 90S preribosome complex involved in production of 18S rRNA and assembly of 40S small ribosomal subunit; ATPase activity stimulated by association with Esp2p
Localization:
Intensity:
Fold change:
Significance:
-
C’ GFP library in SD
below threshold18.25 -
N' NOP1pr-GFP in SD

nucleus,nucleolus0 -
N' TEF2pr-mCherry in SD

nucleus,nucleolus131.013 -
N' NATIVEpr-GFP in SD
nucleus,nucleolus52.7974 -
N' TEF2pr-VC and Cyto-VN in SD

nucleus,nucleolus39.3902 -
C’ GFP library in SD+DTT
cytosol13.890.76No -
C’ GFP library in SD+H2O2

cytosol16.410.89No -
C’ GFP library in Starvation Media

cytosol12.330.67No -
C’ GFP library on the background of Pup2-DaMP

below threshold -
C’ GFP library on the background of CCT mutant

below threshold17.63820.96642No
